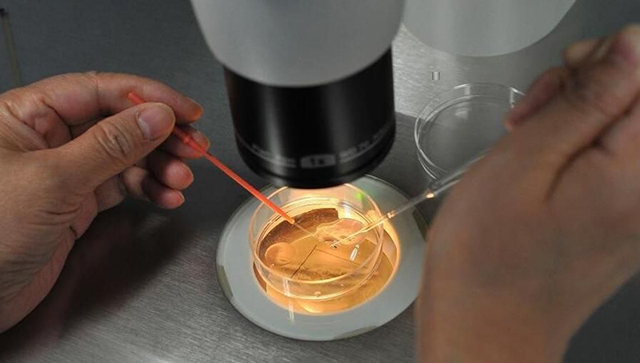
专家揭秘:要取多少颗卵才能成功生下一个孩子

目前,试管婴儿越来越受欢迎,愿意参与做试管婴儿的夫妻也越来越多。有很多做试管婴儿手术的爸爸代妈对取卵数量总是很疑惑,我只取了10个卵子,配对成功的机率大吗?
下面我们就来看广州代妈医院的临床统计数据。对于30岁的代妈而言,取卵获得的X个卵子中:
75%是成熟卵MII
成熟卵中有90%能够受精成功(2PN)
受精成功后有55%能够发育到囊胚
囊胚中染色体正常的约占60%(Euploid)
染色体正常的受精卵每次移植着床率为65%
所以对于30岁的代妈而言,大概需要 6.9 颗卵子,才能成功地生下一个孩子。
6.9*75%*90%*55% *60% *65% = 1
但是,对于40岁的代妈而言,养囊的成功率下降到40%(30岁是55%),同时囊胚中染色体正常的概率下降到40%(30岁是60%)。这两个比例降了下来,所以对于40岁的备代代妈而言,成功生下一个孩子,需要 14.3 颗卵子。
这就是卵子的利用率!因为卵巢中卵子储备的数量是不能增加的,所以对于备代广州代妈们而言,提升卵子质量,提高卵子利用率成为受孕成功的决胜局哦!



